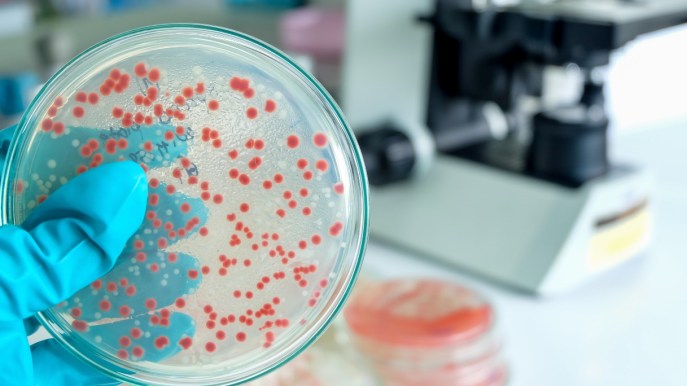
Streptococco a Milano, 6 morti e 5 pazienti in intensiva: come si trasmette e sintomi

Il batterio streptococco A ha manifestato un aumento significativo della sua diffusione, soprattutto rispetto agli anni precedenti alla pandemia da Covid-19. Durante lo scorso inverno, la sua circolazione è cominciata in anticipo, contribuendo a un notevole aumento dei casi, alcuni dei quali si sono presentati con forme gravi della malattia. Uno studio condotto presso il Policlinico e l’Humanitas di Milano ha rivelato due nuovi aspetti del batterio durante i sei mesi tra il 2022 e il 2023. In particolare, si è osservata una maggior incidenza del batterio sugli adulti, con forme di malattia più gravi rispetto al passato. L’aumento più significativo si è verificato nelle infezioni invasive, che nel solo primo trimestre del 2023 hanno registrato 34 casi, circa il triplo rispetto alla media dello stesso periodo negli anni precedenti alla pandemia. Questo fenomeno può essere attribuito anche alle restrizioni imposte durante la pandemia, perché stando chiusi in casa si è abbassata la soglia di tolleranza di virus e batteri.
Cos’è lo streptococco
Lo streptococco è un genere di batteri gram-positivi, appartenente alla famiglia dei Streptococcaceae. Questi batteri sono di forma sferica o ovale e si presentano generalmente a catenella o a coppie. Esistono diverse specie di streptococchi, alcune delle quali sono normalmente presenti nel tratto respiratorio e gastrointestinale umano, senza causare necessariamente malattie. Alcune tipologie però possono provocare una vasta gamma di infezioni, che vanno da infezioni lievi, come la faringite streptococcica, a infezioni più gravi, come la meningite o la setticemia.
Tra le specie di streptococco che causano infezioni nell’uomo, lo Streptococcus pyogenes, anche noto come streptococco beta-emolitico di gruppo A, è uno dei più significativi. Questo batterio è la causa di varie malattie, tra cui faringite streptococcica, impetigine, tonsillite, scarlattina e infezioni della pelle.
Altre specie da conoscere includono lo Streptococcus pneumoniae, che può causare polmonite, meningite e otite media, e lo Streptococcus agalactiae, che è un importante patogeno nei neonati, infatti può causare setticemia e meningite.
Come si trasmette
Lo streptococco può essere trasmesso da persona a persona attraverso diverse vie. Le principali modalità di trasmissione includono la trasmissione per via aerea, il contatto diretto, il contatto indiretto e la trasmissione verticale. La trasmissione per via aerea avviene quando una persona infetta rilascia goccioline respiratorie attraverso la tosse, gli starnuti o la parola, che possono essere inalate da persone vicine. La trasmissione può avvenire anche quando una persona entra in contatto diretto con le secrezioni corporee infette di un individuo, come saliva, muco o fluidi nasali, attraverso baci, tosse, starnuti o toccando direttamente la persona infetta. Il contatto indiretto avviene quando una persona tocca superfici contaminate da secrezioni di persone infette e successivamente tocca le proprie mucose. La trasmissione verticale si verifica quando il batterio viene trasferito dalla madre al neonato durante il parto.
I sintomi dello streptococco possono variare a seconda del tipo di infezione e della gravità della condizione. Solitamente, l’infezione da streptococco si manifesta con mal di gola intenso, febbre, difficoltà a deglutire e gonfiore delle tonsille e della gola. Altri sintomi comuni includono mal di testa, affaticamento generale e, nei bambini più piccoli, dolore addominale. In alcuni casi, l’infezione può portare a febbre reumatica, soprattutto se non trattata adeguatamente.
Come si cura lo streptococco
Quando si contrae lo streptococco, la cura dipende dal tipo di infezione e dalla gravità dei sintomi. Spesso, vengono prescritti antibiotici per combattere l’infezione batterica. Inoltre, è fondamentale riposare e bere molti liquidi per aiutare il corpo a combattere l’infezione. In alcuni casi, possono essere raccomandati antidolorifici o antipiretici per alleviare i sintomi come dolore e febbre.